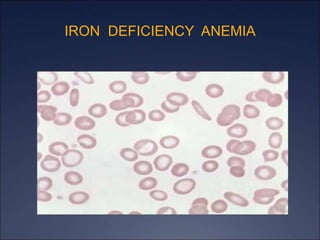
IRON DEFICIENCY ANEMIA

The document discusses iron deficiency anemia, including its causes, symptoms, physical exam findings, diagnostic testing, disease progression, treatment, and comparisons to other anemias. It provides details on lab tests like complete blood count, serum iron, ferritin, and TIBC levels as well as peripheral smear and bone marrow biopsy findings. The morphology, degrees, and gold standard diagnosis of iron deficiency anemia are outlined based on microcytic hypochromic features and lack of iron in bone marrow.